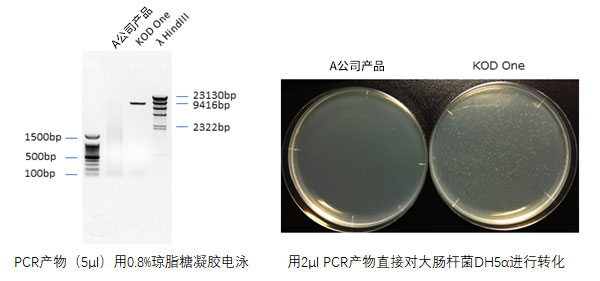
a3bf0c0e2f34e3459e386e9f3d0ccbe6.jpg

数据提供: 广岛大学医齿药保健学研究科 产科妇科教研室 助教 杉本 润
<实验目的>
在哺乳动物细胞用表达载体中对重组基因A进行了氨基酸替换的3个碱基突变。
<实验方法>
【样品】
质粒:哺乳动物细胞用表达载体(约7.1kb):重组基因A(约1.8kb)的质粒
【样品的制备方法】
用Qiagen midi kit抽提、纯化的质粒DNA
【基因名称与目的片段长度】
基因A : 1.8kb, Vector: 7.1kb
【引物】
突变导入用引物Forward (31 base)
突变导入用引物Reverse (31 base)
【反应液组分】 【PCR循环】
灭菌蒸馏水 X 98℃ 10sec.
KOD One PCR Master Mix 12.5 μl 55℃ 15sec. 30cycles
引物Forward 0.2μM 72℃ 40sec.
引物Reverse 0.2μM
Template 50pg
-----------
Total 25
【检测仪器】
GeneAmp PCR system 9700
<结果・讨论>
<感受・建议等>
迄今为止,本研究室使用的哺乳动物细胞用表达载体中,在重组基因序列中进行突变导入时非常困难。由此,在不同载体(pGEM-T等)中的重组基因中导入突变后,切出包含突变的DNA片断,需要再对哺乳动物细胞用表达载体进行克隆。但是,通过使用KOD One,能够直接导入突变,从而缩短了时间、人力。另外,突变的导入效率在测试的几个克隆中是100%,并确认在突变位点附近序列中没有PCR错配。








